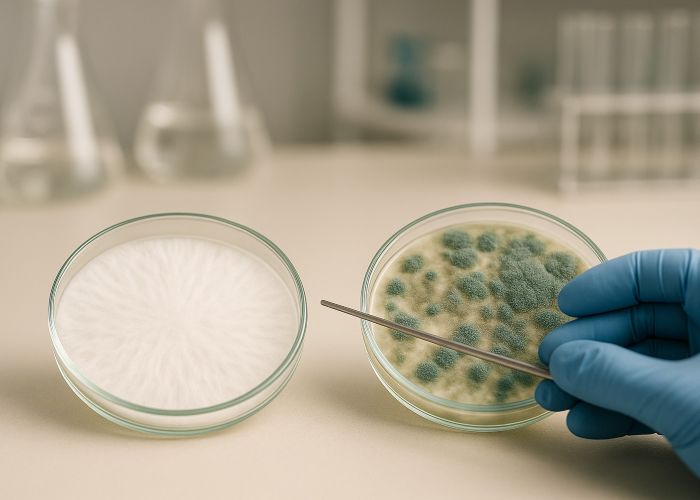

Для микологов, особенно тех, кто занимается культивированием псилоцибиновых грибов, слово «триходерма» звучит почти как приговор. Это не просто очередной контаминант из длинного списка возможных угроз — это настоящий ночной кошмар любого гровера. Микроскопическая плесень, способная за считаные дни полностью уничтожить колонию, не оставляя ни одного шанса на спасение.
Причем делает она это без шума: без характерного запаха гнили, без ярко выраженного визуального предупреждения — просто в какой-то момент на субстрате появляется мохнатая зеленовато-белая масса. Ни примордий, ни грибных шапочек — только вата из спор, которые уже ищут, что захватить дальше.
Кто такая триходерма, как именно она действует, откуда появляется и почему именно ее считают врагом номер один — разберемся по пунктам.
Что такое триходерма и почему она такая агрессивная
Триходерма — это род плесневых грибов из отдела Ascomycota, в который входит множество видов, но для микологов на практике чаще всего «звучат тревогу» по поводу Trichoderma harzianum, T. viride и особенно зловещей T. aggressivum. Эти грибы повсеместны: они обитают в почве, на гниющей древесине, в компосте, навозе и любых других источниках органики. Однако их особенности делают их не просто фоновыми обитателями субстрата — триходерма ведет агрессивный, наступательный образ жизни. Ее биология буквально заточена под захват и доминирование.
Главное отличие триходермы от большинства других плесеней — это выраженный микопаразитизм. Ее цель — не просто разлагать органику, а разрушать других грибов. Она проникает в их мицелий, расщепляет его на клеточном уровне и использует как питательный субстрат. В лабораторных или гроу-условиях ее экспансия происходит пугающе быстро: триходерма способна колонизировать питательную среду за несколько часов. При этом она задействует целый арсенал биохимического оружия.
Ферменты вроде целлюлаз, хитиназ и глюканаз расщепляют клеточные стенки грибов, а специфические метаболиты — например, виридины и харзианолы — подавляют рост чужого мицелия, действуя как природные фунгициды. Для Psilocybe cubensis и других псилоцибиновых грибов это означает катастрофу: триходерма способна полностью уничтожить мицелий как на стадии инкубации, так и в момент, когда вы уже ждете появления примордий. Она не просто конкурирует — она устраняет.
Как проявляется заражение
Начинается заражение незаметно. На поверхности субстрата появляется маленькое белесое пятнышко — на первый взгляд ничем не отличающееся от нормального роста мицелия Psilocybe. Однако триходерма выдает себя скоростью и агрессией. Если мицелий псилоцибиновых грибов развивается постепенно, аккуратно, локализованно, то триходерма сразу рвется в рост, выходя за границы инокулированной зоны и расползаясь по поверхности ковром рыхлого белого мицелия.
Сначала структура может казаться безобидной — такой же пушистой, как молодые нити мицелия. Но при ближайшем рассмотрении заметно, что у триходермы она более рыхлая, не дает характерных плотных ризоморфных нитей и не обладает блеском, присущим здоровому Psilocybe. Этот налет похож скорее на вату или войлок. Через короткое время, иногда буквально за ночь, налет меняет цвет — появляются участки с серо-зеленым или оливковым оттенком. Это сигнал к спорам: триходерма начала споруляцию.
Когда поверхность покрывается характерной зеленой пудрой — это уже споры, и счет пошел на минуты. При этом они могут распространяться по всему инкубационному или плодоносящему пространству, оседая на стенках, перчатках, воздухозаборниках и инструментах. Даже если визуально поражена лишь часть субстрата, заражен может быть уже весь объем. Как только замечена спороносящая стадия триходермы, такую культуру нужно немедленно изолировать и утилизировать — спасти ее уже невозможно.
Почему триходерма — именно враг, а не просто контаминант
Контаминанты в грибоводстве — явление неприятное, но далеко не всегда фатальное. Бактерии, дрожжи, обычные плесени вроде пенициллов или аспергиллов чаще всего лишь замедляют рост мицелия, ухудшают аэрацию субстрата, вызывают неприятные запахи. Они могут быть локализованы, остановлены или подавлены — особенно если гровер опытен и успел среагировать. Триходерма же — из другого мира. Это не просто попутчик, мешающий грибам расти. Это целенаправленный, эволюционно отточенный грибной убийца.
В отличие от большинства плесневых грибов, которые конкурируют пассивно — вытесняя, но не разрушая, — триходерма ищет активного контакта. Ее гифы буквально прощупывают мицелий других грибов, обвивают его, выделяют литические ферменты, разрушающие клеточные стенки, и высасывают содержимое клеток. Этот процесс называется микопаразитизмом, и триходерма в нем — один из самых успешных исполнителей. Она не просто делит пространство — она превращает чужой мицелий в собственную пищу.
Кроме того, у триходермы есть дополнительный набор биохимических трюков. Она способна подкислять субстрат, выделяя органические кислоты, меняя pH до уровней, неудобных или губительных для других грибов. А ее устойчивость к большинству домашних дезинфектантов — еще один козырь. Обработка поверхности перекисью, уксусом, даже растворами на основе спирта может не остановить ее распространение.
Но, пожалуй, самое коварное — это ее споры. Мелкие, летучие, практически невидимые глазу, они легко поднимаются в воздух при малейшем движении воздуха или при открытии контейнера, оседают на всех поверхностях и ждут своего часа. Более того, они устойчивы к ультрафиолету и высоким температурам, а это значит, что дезинфекция помещения, в котором однажды была зафиксирована триходерма, превращается в отдельную микологическую эпопею. Именно поэтому триходерму боятся не как случайную плесень, а как врага — коварного, живучего и стратегически опасного.
Где чаще всего появляется триходерма
Триходерма — не та гостья, которую можно полностью исключить из уравнения грова. Ее споры повсеместны, и даже при максимально чистом рабочем процессе можно однажды обнаружить знакомое бело-зеленое пятно. Однако существуют условия и ошибки, которые значительно повышают риск ее появления.
- Чаще всего заражение связано с нарушениями в подготовке субстрата. Например, при пастеризации перегрев может сыграть злую шутку: если температура была недостаточной для уничтожения спор, но слишком низкой для эффективной термообработки, вы создаете идеальные условия для триходермы — тепло, влажно и стерильно, без конкурентов. Она быстро воспользуется этим.
- Второй типичный сценарий — грязные инокулянты. Это может быть что угодно: капля на игле шприца, непродезинфицированная банка, прилипшая спора на скальпеле, плохо промытое зерно. Если хотя бы один элемент попал в бокс с «подарком» от триходермы, заражение может начаться еще на стадии инкубации.
- Третий фактор — плохая вентиляция. Застой воздуха, особенно при высокой влажности, создает зону, в которой триходерма чувствует себя комфортно. Без циркуляции споры легко оседают и начинают развиваться. Особенно если в помещении тепло и влажно — типичная среда для грибной фермы.
- Не стоит забывать и о повторном использовании субстратов или упаковок. Даже если визуально все чисто, споры могут сохраняться в порах пластика или на внутренней поверхности мешков, особенно если не проводилась полноценная стерилизация. Старая тара, фильтры в банках, лотки из-под предыдущих гровов — все это потенциальные носители спор.

И, наконец, важное уточнение: наличие чистой лаборатории не является гарантией. Споры триходермы могут попасть внутрь помещения с обувью, на одежде, с частицами пыли, волосами, инструментами — словом, с чем угодно. Они устойчивы, живучи и прекрасно переживают неблагоприятные условия. Именно поэтому абсолютной защиты не существует. Можно лишь снизить вероятность, но не исключить ее полностью.
Как предотвратить заражение
Главное правило для всех, кто работает с мицелием, особенно псилоцибиновых грибов, звучит просто: стерильность — это не этап, а образ жизни. Но в деле защиты от триходермы одной чистоты мало. Нужна системная, продуманная гигиена с учетом коварства противника.
- Тепловая обработка субстрата — первый и критически важный шаг. Минимум — пастеризация при температуре 60–70 °C не менее одного часа. Но лучший вариант — автоклавирование, которое гарантированно уничтожает споры, даже глубоко спрятанные в плотных слоях материала. Не стоит надеяться на «авось» — триходерма не прощает недогрева.
- Инструменты, банки, лотки и поверхности нужно дезинфицировать комплексно. Спирт 70% — это только базовая линия. Эффективнее сочетание спирта с перекисью водорода, изопропанолом или хлоргексидином. Не забывайте о крышках, внутренней стороне банок и всех точках контакта — именно туда чаще всего прячутся споры.
- Работа с инокуляцией должна проводиться исключительно в условиях, где воздух контролируется: ламинарный бокс, или хотя бы работа рядом с пламенем (спиртовка, газовая горелка), создающим стерильную восходящую струю. Открытие банок в обычной комнате, даже «чистой» — открытое приглашение для контаминантов.
- Руки и перчатки нужно обрабатывать не реже, чем инструменты. Каждое прикосновение, каждый вдох в сторону открытой банки — потенциальный путь заражения. Маска и шапочка — не паранойя, а базовая защита от собственных волос, дыхания и микрофлоры.
- Что касается зернового мицелия — тут важно помнить: не существует универсального доверия. Даже красивый, плотный и чистый на вид мицелий из магазина может содержать споры триходермы. Работать стоит только с теми поставщиками, чья стерильность проверена временем и личным опытом. Все остальное — лотерея.
После любого цикла, особенно неудачного, нужно обязательно проводить глубокую санацию помещения. Все поверхности, боксы, полки, инкубаторы обрабатываются 5% раствором перекиси водорода, белизной или хлорсодержащими средствами. Не забудьте про смену фильтров и мембран на банках — даже если они «в порядке», они могли аккумулировать споры. Профилактика — единственное, что стоит между вами и триходермой. И она не терпит компромиссов.

Можно ли спасти зараженный субстрат?
Увы, но в подавляющем большинстве случаев — нет. Если триходерма уже проявилась на поверхности субстрата, это означает, что ее гифы давно распространились внутри, задушили мицелий и начали колонизацию. Все «народные методы» вроде соскребания зараженного участка, присыпки солью, гипсом, корицей или перекисью не решают главную проблему — глубинного заражения. Они могут замедлить рост плесени локально, но не остановят ее распространение.
Даже если визуально часть мицелия псилоцибинового гриба выглядит живой, это обманчиво. Он уже находится под постоянным биохимическим давлением: триходерма вырабатывает токсины, разрушает клеточные стенки, изменяет pH среды. В таких условиях мицелий не способен нормально развиваться, теряет жизнеспособность, а если и переходит к плодоношению — выдает уродливые, миниатюрные, малоактивные плодовые тела, часто с признаками дегенерации.
Более того, как только триходерма начинает споруляцию, помещение автоматически становится «грязным». Даже если вы изолируете зараженную банку, споры уже поднялись в воздух и осели на поверхности — в том числе на новых банках, инструментах и одежде. А значит, даже идеально обработанная новая партия рискует быть зараженной еще до начала инкубации.
Поэтому основной совет здесь один: если вы точно идентифицировали триходерму — не спасайте, а изолируйте и утилизируйте. Не открывайте контейнеры в помещении. Лучше вынести их герметично закрытыми и утилизировать на улице. И сразу после — санобработка всего, что могло контактировать со спорами. Спасти зараженный субстрат почти невозможно. А вот не дать спорам триходермы перекинуться на следующую попытку — жизненно важно.
Парадокс триходермы: полезна в агрономии, убийственна в микологии
На первый взгляд, возникает путаница: как один и тот же организм может считаться полезным в одних условиях и губительным — в других? Но именно это и делает триходерму таким интересным (и опасным) объектом. В агрономии и биозащите растений она считается почти что «золотым стандартом» природного антагониста патогенов. Ее активно используют в качестве биоконтрольного агента для подавления фузариоза, ризоктонии, питиума и других заболеваний, поражающих корневую систему.
Триходерма в почве помогает растениям укрепить иммунитет, ускоряет рост, способствует более активному усвоению питательных веществ, а также стабилизирует микробиом в ризосфере. В некоторых случаях она даже улучшает прорастание семян и увеличивает урожайность. По сути, в растениеводстве триходерма — союзник, способный заменить химические фунгициды без вреда для окружающей среды.
Но в микологии, особенно в контексте культивации псилоцибиновых грибов, ситуация диаметрально противоположна. Здесь любой контакт с триходермой равен катастрофе. Псилоцибиновые грибы не обладают защитными механизмами против такого агрессора. Их мицелий — мягкий, чувствительный, неспособный выдержать ферментативную атаку и биохимическую конкуренцию. То, что для растения — защита, для гриба — смертельная угроза.
Именно поэтому советы, кочующие с огородных форумов в грибные чаты — вроде «добавьте триходерму в компост, будет полезно» — в условиях грибоводства превращаются в рецепт гарантированного провала. Особенно это опасно в микс-средах, где используют почву, перегной или органические добавки. Один пакет «садового биоконтроля» может уничтожить всю грибницу за ночь.
Этот парадокс — наглядное напоминание о том, что полезность микроорганизма всегда зависит от контекста. Триходерма — отличная помощница в саду, но в гроубоксе с мицелием Psilocybe она ведет себя как безжалостный хищник.
Заключение
Триходерма — это не просто плесень. Это умелый, целенаправленный и крайне живучий микропаразит, обладающий целым арсеналом ферментов и токсинов. Она не просто конкурирует за питание — она уничтожает, адаптируется и распространяется. И делает это с поразительной скоростью. В грибоводстве, особенно при культивации чувствительных видов вроде Psilocybe cubensis, именно триходерма становится главной угрозой, способной свести на нет месяцы работы.
Борьба с ней практически всегда заканчивается поражением. Поэтому важнейшей стратегией становится не реакция, а профилактика: грамотная термическая обработка, стерильность на всех этапах, надежные инокулянты и полная санация после каждого цикла. Гров, где все сделано «на глаз», — идеальная мишень для спор триходермы.
В мире волшебных грибов она заслуженно носит титул врага номер один. И лучшее, что может сделать гровер — не искать способы подавить ее, а сделать все возможное, чтобы она не появилась вообще. Потому что если уж триходерма пришла — она не уходит просто так.
Источники:
- Fungi Academy. Mushroom contamination: How to spot and what to do.
- Grow Magik. Trichoderma in monotub mushroom growing.
- Alchimia Grow Shop. Contamination in magic mushroom cakes, what to do and how to prevent it?






















